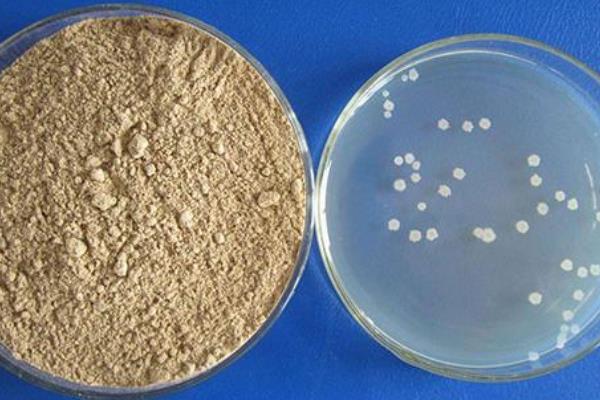
枯草芽孢杆菌最怕什么？附作用与禁忌及介绍

枯草芽孢杆菌是一种多功能的微生物,能间接抑制其它致病菌生长,提高动物体(人体)内干扰素和巨噬细胞的活性。枯草芽孢杆菌对于阳光中的紫外线敏感,不可在阳光爆晒撒施,可以在阴天或清晨、傍晚施用于土壤中;与没有腐熟的农家肥施入地里,会产生2次发酵升温,高温会杀死微生物,会影响菌种的活性和发挥。

一、枯草芽孢杆菌的介绍
1、枯草芽孢杆菌在污水处理,以及生物肥发酵或发酵床制作中应用广泛,是一种多功能的微生物。
2、可用于市政和工业污水处理,工业循环水处理,腐化槽、化粪池等处理,畜牧养殖动物废料、臭味处理,粪便处理系统,垃圾、粪坑、粪池等处理。
3、可用于畜牧、家禽、特种动物及宠物养殖。
4、可以与多种菌种混配,在农业生产中具有重要作用。

二、枯草芽孢杆菌的作用
1、枯草芽孢杆菌菌体在生长过程中,所产生的枯草菌素、多粘菌素、制霉菌素和短杆菌肽等活性物质,对致病菌或内源性感染条件的致病菌,有明显的抑制作用。
2、枯草芽孢杆菌会迅速消耗肠道中的游离氧,导致肠道低氧,促进有益厌氧菌生长,间接抑制其它致病菌生长。
3、能刺激动物(人体)免疫器官的生长发育,激活T、B淋巴细胞,提高免疫球蛋白和抗体水平,增强细胞免疫和体液免疫功能,提高群体免疫力。

4、枯草芽孢杆菌菌体自身合成α-淀粉酶、蛋白酶、脂肪酶和纤维素酶等酶类,在消化道中与动物体(人体)内的消化酶类一同发挥作用。
5、能合成维生素B1、B2、B6、烟酸等多种B族维生素,提高动物体(人体)内干扰素和巨噬细胞的活性。
6、枯草芽孢杆菌对特殊菌体进行促芽孢和微胶囊包被处理,在芽孢状态下稳定性好,能耐氧化;耐挤压;耐高温,能长期耐60℃的高温,在120℃的温度下能存活20分钟;耐酸碱,在酸性胃环境中能保持活性,而且耐唾液和胆汁的攻击,是微生物中可100%直达大小肠的活菌。

三、使用枯草芽孢杆菌的禁忌
1、在使用枯草芽孢杆菌前,一定要兑水激活,其效果要远比直接撒的效果好。
2、避免开袋后长期不用,要注意密封储存,避免菌种流失,因为开袋后长期不用,会有其他细菌侵入袋内,使菌种发生改变,影响其使用效果。
3、 枯草芽孢杆菌不宜与杀菌剂、杀虫剂、除草剂同时使用,也不可在使用后在对土壤消毒。
4、 枯草芽孢杆菌适宜的土壤湿度为60%左右,所以要注意不要在过分干旱时使用。
5、 枯草芽孢杆菌对于阳光中的紫外线敏感,不可在阳光爆晒撒施,可以在阴天或清晨、傍晚施用于土壤中。
6、 枯草芽孢杆菌施入土壤后,有1个菌群繁殖壮大的过程,所以要在果树跟系开始生长前使用。
7、避免和没有腐熟的农家肥混用,与没有腐熟的农家肥施入地里,会产生2次发酵升温,高温会杀死微生物,会影响菌种的活性和发挥。